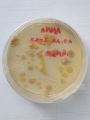
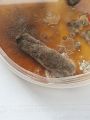

Slime mold versus AI
Slime mold is a type of single-celled organism that can come together to form a larger structure. When slime mold spreads, it moves in a pattern that helps it explore its environment. It leaves behind a slime trail that helps it communicate and navigate.
Scientists are interested in slime mold because it can solve complex problems and find the most efficient route to food, even without a brain. This ability has led to research on using slime mold as a model for artificial intelligence and decentralized computing. This means that we could use slime mold to help computers solve problems and make decisions in a more efficient and intelligent way.
For our project, we decided to use one of the most popular AI programs, available online, ChatGPT. Our goal was to load data based on our observations in the laboratory into the program and compare the results. The website is programmed to find the most efficient and intelligent way to describe the living organism, metaphorically, to the slime mold spreading, thriving and dying as it webs through its surroundings in search of nutrients. The following poems are generated from our notes by ChatGPT:
Green slime mold poem
A mold of slime, it starts to grow
Webbing surroundings, oh so slow
It breathes and feeds, with every day
Expanding its reach, in its own way
Its life span short, a fleeting sight
Gorging on nutrients, with all its might
But soon it fades, its time is near
Its death approaching, ever clear
And so it goes, this mold of slime
A life so brief, but so sublime
A lesson learned, in nature's lore
That life is precious, and nothing more.
Slime mold spreading
he slime mold crawls across the forest floor,
Its tendrils reaching out like fingers searching for more,
A masterpiece in motion, a work of art,
As it spreads across the ground, igniting the heart.
Its soft, delicate body, moves with grace,
A dance of life, a captivating embrace,
In shades of yellow, orange, and gold,
Its beauty and elegance, can never be told.
It creeps and crawls, finding its way,
Intricately weaving, every single day,
A living, breathing piece of art,
A wonder of nature, a work of heart.
The spreading of slime mold, a stunning sight,
An artistic masterpiece, that fills the light,
A natural creation, beyond compare,
A living testament, to the beauty we share.
To complete the circle, we created a digital drawing as a translation of the generated text into graphics. The video shows the process of hand-drawing the life span of slime mold. It is a combination of learning and observing living organism, but also of human and artificial imagination.
Workshop on biofilms with Katja Bühler
Introduction
Within the framework of the Workshop, Dr. Katja Bühler introduced us to the interesting world of living organisms in the form of a presentation.
DIY vinegar mother
The first active task of the day was to put into practice the newly acquired knowledge about fermentation used in the food industry and to prepare our own vinegar mother. Even after they were made, we monitored and documented the life and development of our mixture.
Colorful nature
The purpose of the next activity was to collect samples of plants and objects in our environment so that we could grow the living organisms found on them in petri dishes. As a result, colonies of very different sizes, shapes, textures and colors were obtained in the petri dishes, whose development was also monitored and documented in the BioLab.
Buffet of fermented foods
We were invited for lunch, where only fermented food was on the table, and we were surprised to see how much this natural process impacts our lives.
Workshop Pocket Science Lab (PSLab): Measurements and Robot Controls with Marco Antonio Gutierrez and Mario Behling
Introduction
During this workshop in January, we learned about the PSLab - Pocket Science Lab -, which is an open-source project. A small hardware extension board enables the collection of measurements and data with the phone or PC through different sensors.
PSLab can function as a:
Oscilloscope I Multimeter I Logic Analyzer I Wave Generator I Power Source I Accelerometer I Barometer I Compass I Luxmeter I ...
Sensor experiments
After learning about the functions and possibilities we started experimenting by connecting the PSLab sensors to the PC and giving commands in Python.
We were using the board as an oscilloscope to graphically display varying electrical voltages. For that, we connected two points on the device and changed the script to generate waves with different characteristics.
first setting: the waves are not visible, and the spectrum needs to be adjusted
adjusted waves
measuring two inputs
changing the displayed wave type
comparing the results to a living organism - ourselves-. Displaying the electrical voltages in our fingers.
conclusion
The experiments during the workshop are showing a small piece of the possible measurements with the small device of PSLab. For the results above only one sensor was used out of hundreds of existing options. The device allows us to understand the invisible factors of our environment without a laboratory or expensive devices. Besides collecting information, like humidity, emissions, sound, or light, the control of servos is also possible. It works as a translator between different mediums, the extracted information can be easily converted into an image, video, or sound. The easy control over a robotic arm holds the potential for quick testing of ideas and sketches, resulting in a high variety of complex artistic outcomes.